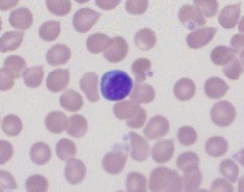
term image
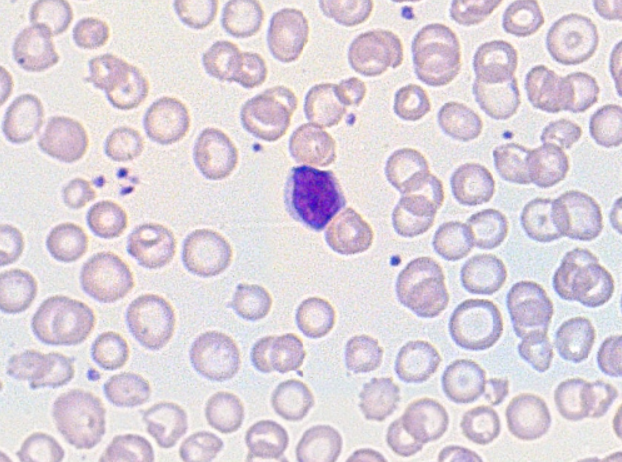
term image
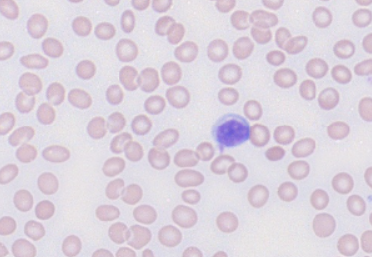
<p>Hint: There’s basophilic stippling</p>
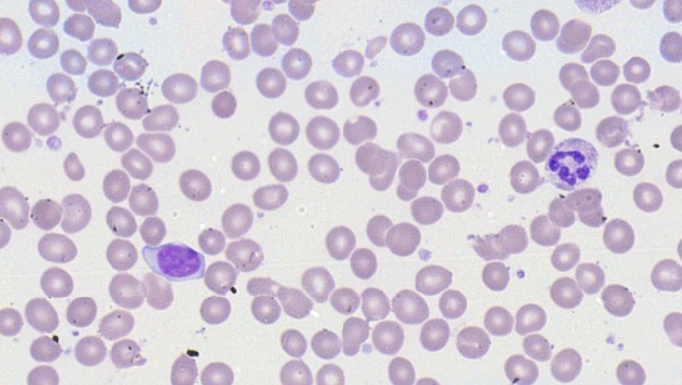
term image
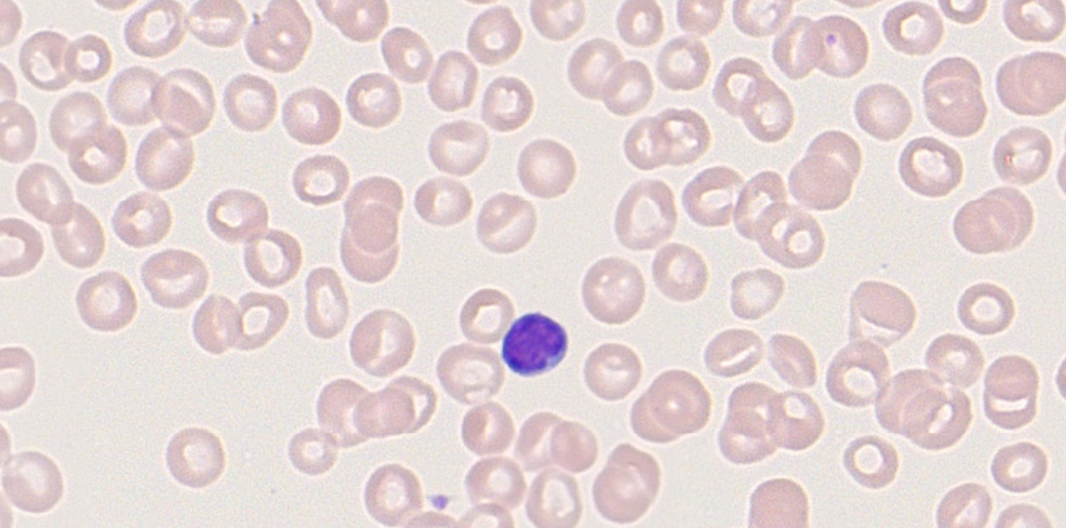
term image
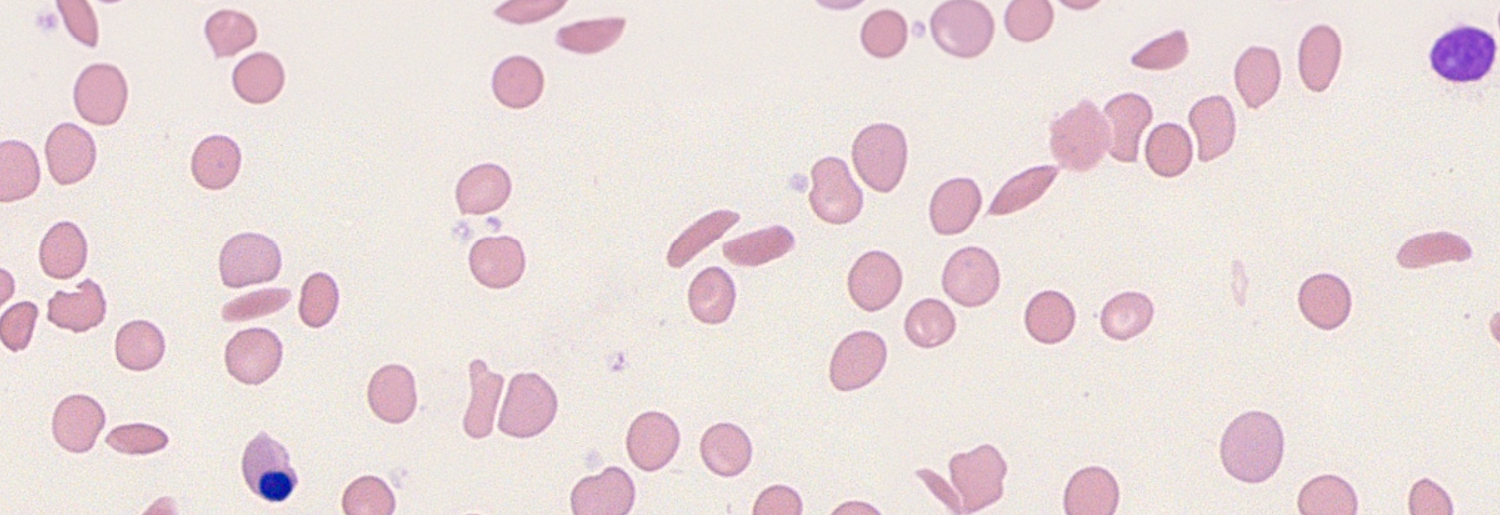
term image
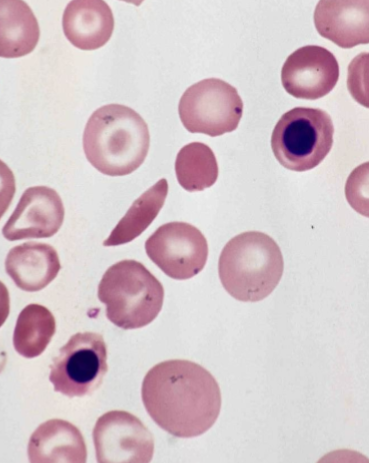
term image
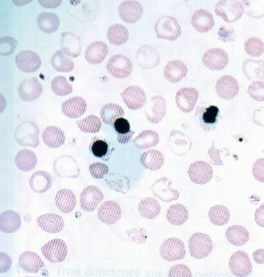
term image
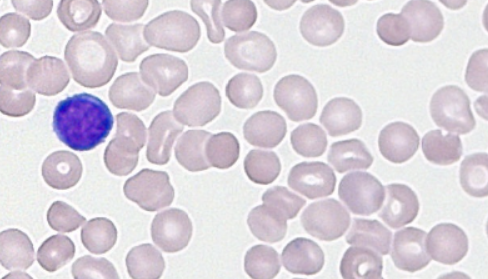
term image
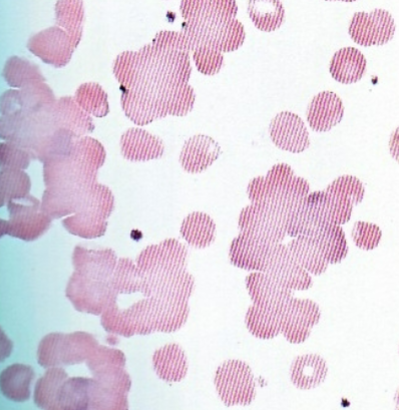
term image
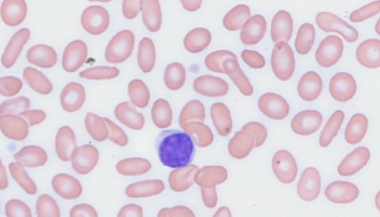
term image
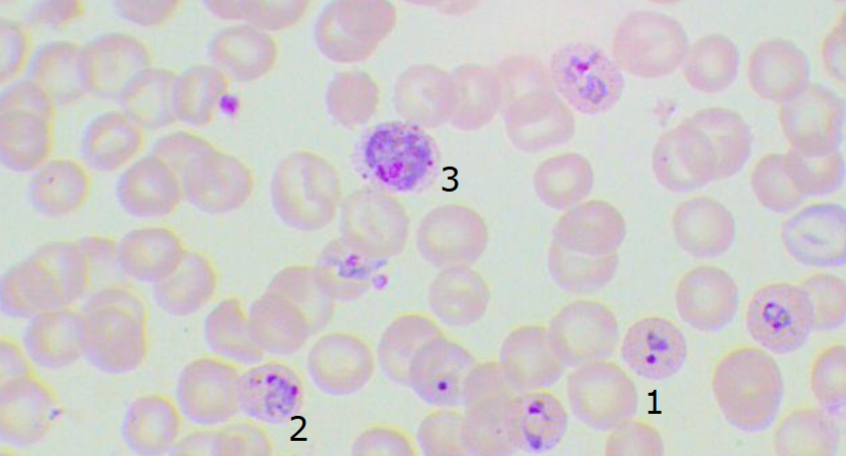
term image
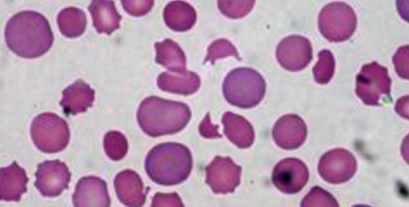
term image
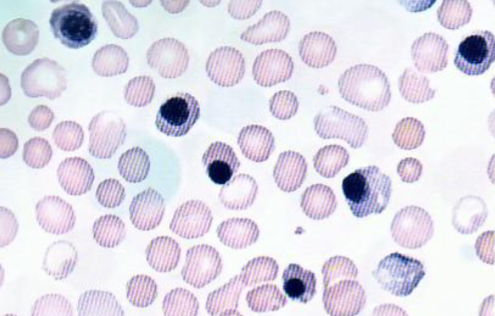
term image

MLSC 2121U Hematology I Final Practical Exam Review
1/15
Earn XP
Description and Tags
Provide: Size & colour, unique characteristics, diagnosis, and differentiating tests
Name | Mastery | Learn | Test | Matching | Spaced | Call with Kai |
|---|
No analytics yet
Send a link to your students to track their progress
16 Terms
Size & colour: Normo, normo
Unique characteristics: N/A
Diagnosis: Normal
Differentiating tests: N/A
Size & colour: Micro, hypo
Unique characteristics: Faint staining, Targets
Diagnosis: IDA/A- or B-thal minor
Differentiating tests: Iron studies, Genetic testing
Hint: There’s basophilic stippling
Size & colour: Micro, hypo
Unique characteristics: Faint staining, Targets, basophilic stippling
Diagnosis: B-thal minor
Differentiating tests: Genetic testing, Hb electrophoresis
Size & colour: Macro, normo
Unique characteristics: Hypersegmented neutrophils, Oval macrocytes
Diagnosis: Megaloblastic anemia
Differentiating tests: B12/Folate assay, Schillings test
Size & colour: Macro, normo
Unique characteristics: Targets, slight decrease and large PLTs, punchout artifact, rare inclusion bodies
Diagnosis: liver disease / alcoholism
Differentiating tests: Liver enzymes, no response to B12 or folate
Size & colour: Normo, normo
Unique characteristics: Decreased WBCs and PLTs
Diagnosis: Aplastic anemia / pancytopenia
Differentiating tests: Bone marrow, decreased RETICs
Size & colour: Aniso, normo
Unique characteristics: Targets, Sickled cells, NRBCs, polychromasia
Diagnosis: HbSS
Differentiating tests: Sickledex pos., Hb electrophoresis
Size & colour: Aniso, normo
Unique characteristics: “Major mess” (Many different shapes and inclusions (except sickle cell), many NRBCs
Diagnosis: B-thal major
Differentiating tests: Iron studies, Hb electrophoresis

Size & colour: Normo, normo
Unique characteristics: Targets, HbC crystals
Diagnosis: HbCC
Differentiating tests: Hb electrophoresis
Size & colour: Normo, normo
Unique characteristics: Many spherocytes, polychromasia, occational NRBCs
Diagnosis: Hereditary spherocytosis
Differentiating tests: Genetic testing, DAT / (direct coombs test) neg., Increased: osmotic fragility, retic, and bili, Decreased: RBC survival
Size & colour: Agglutinated
Unique characteristics: Agglutination, short and grainy smear
Diagnosis: Cold agglutinin disease
Differentiating tests: DAT / (direct coombs test) pos., thermal amplitude titre
Size & colour: Normo, normo
Unique characteristics: Many elliptocytes
Diagnosis: Hereditary elliptocytosis
Differentiating tests: Genetic (family) studies

Size & colour: Normo, normo
Unique characteristics: Parasitemia level - rings, gametocytes (banana shaped)
Diagnosis: P. falciparum
Differentiating tests: Thick and thin smear, malaria rapid test, parasitemia level
Size & colour: Normo, normo
Unique characteristics: Parasitemia level - rings, schizonts, gametocytes
Diagnosis: Non - P. falciparum
Differentiating tests: Thick and thin smear, malaria rapid test, parasitemia level
Size & colour: Normo, normo
Unique characteristics: Fragments, decreased PLTs, spherocytes, polychromasia
Diagnosis: Microangiopathic hemolytic anemia (MAHA)
Differentiating tests: Rinal and coagulations studies
Size & colour: Normo, normo
Unique characteristics: Very short and thick slide, NRBCs, targets
Diagnosis: Hemolytic disease of the newborn
Differentiating tests: Antibody testing, DAT / (direct coombs test)